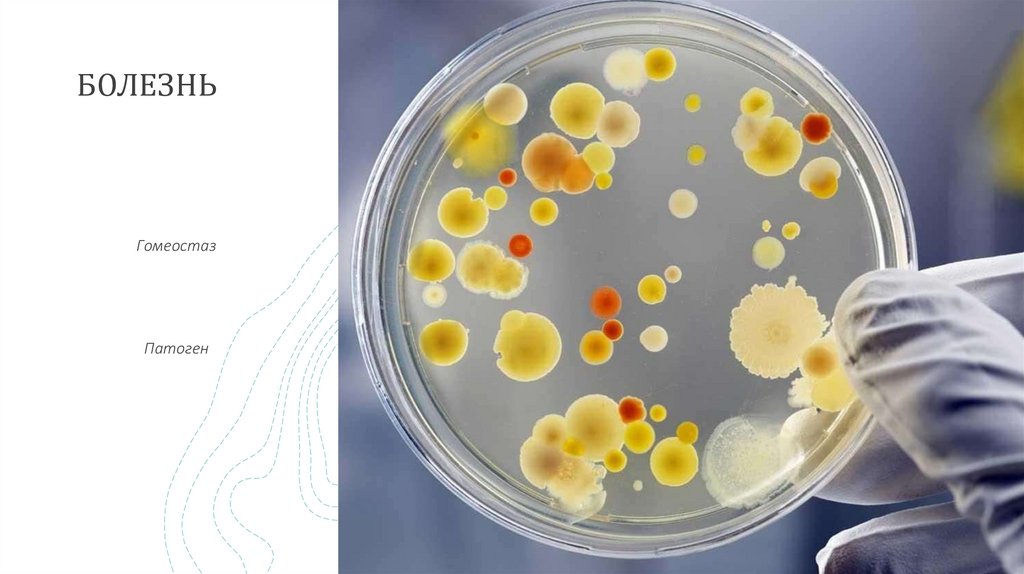

Похожие презентации:
Почему могут вернуться заболевания прошлых лет
1.
ПОЧЕМУ МОГУТ ВЕРНУТЬСЯ ЗАБОЛЕВАНИЯПРОШЛЫХ ЛЕТ
Сарафанникова Анастасия
2.
БОЛЕЗНЬГомеостаз
Патоген
Заголовок презентации
2
3.
ПРИЧИНЫ ПОЧЕМУ ВЫЛЕЧЕННАЯ БОЛЕЗНЬ МОЖЕТВЕРНУТЬСЯ
3
4.
ЗАБОЛЕВАНИЕЗаболевание — это не просто наличие симптомов
или диагноз, это комплексное состояние, которое
затрагивает все аспекты жизни человека и требует
комплексного подхода к диагностике и лечению
4
5.
СПОСОБЫ БОРЬБЫ С БОЛЕЗНЬЮСоблюдение
поддерживающег
о режима дня и
рациона
Лечение
антибиотиками
Симптоматичес
кое лечение
Укрепление
иммунитета
Вакцинация
5
6.
ПОДВЕДЕНИЕ ИТОГОВЭффективная борьба с инфекционными
заболеваниями требует комплексного
подхода, включающего медицинские
вмешательства, изменения в образе жизни и
профилактические меры.
Обязательно консультируйтесь с врачом
перед началом лечения и следуйте его
рекомендациям для достижения наилучших
результатов.
6
7.
СПАСИБОСарафанникова
Анастасия Сергеевна,
обучающаяся 9 «В»
класса
МАОУ «гимназия № 1
города Белогорска»
7

Медицина
Медицина








